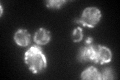
YDL174C

View description
D-lactate dehydrogenase, oxidizes D-lactate to pyruvate, transcription is heme-dependent, repressed by glucose, and derepressed in ethanol or lactate; located in the mitochondrial inner membrane
Localization:
Intensity:
Fold change:
Significance:
-
C’ GFP library in SD

mitochondria34.24 -
N' NOP1pr-GFP in SD

mitochondria171.33 -
N' TEF2pr-mCherry in SD

mitochondria192.259 -
N' NATIVEpr-GFP in SD

mitochondria30.744 -
N' TEF2pr-VC and Cyto-VN in SD

#N/A0 -
C’ GFP library in SD+DTT
mitochondria41.331.2No -
C’ GFP library in SD+H2O2

mitochondria33.470.97No -
C’ GFP library in Starvation Media

mitochondria26.480.77No -
C’ GFP library on the background of Pup2-DaMP

mitochondria -
C’ GFP library on the background of CCT mutant

mitochondria32.82010.958207No
